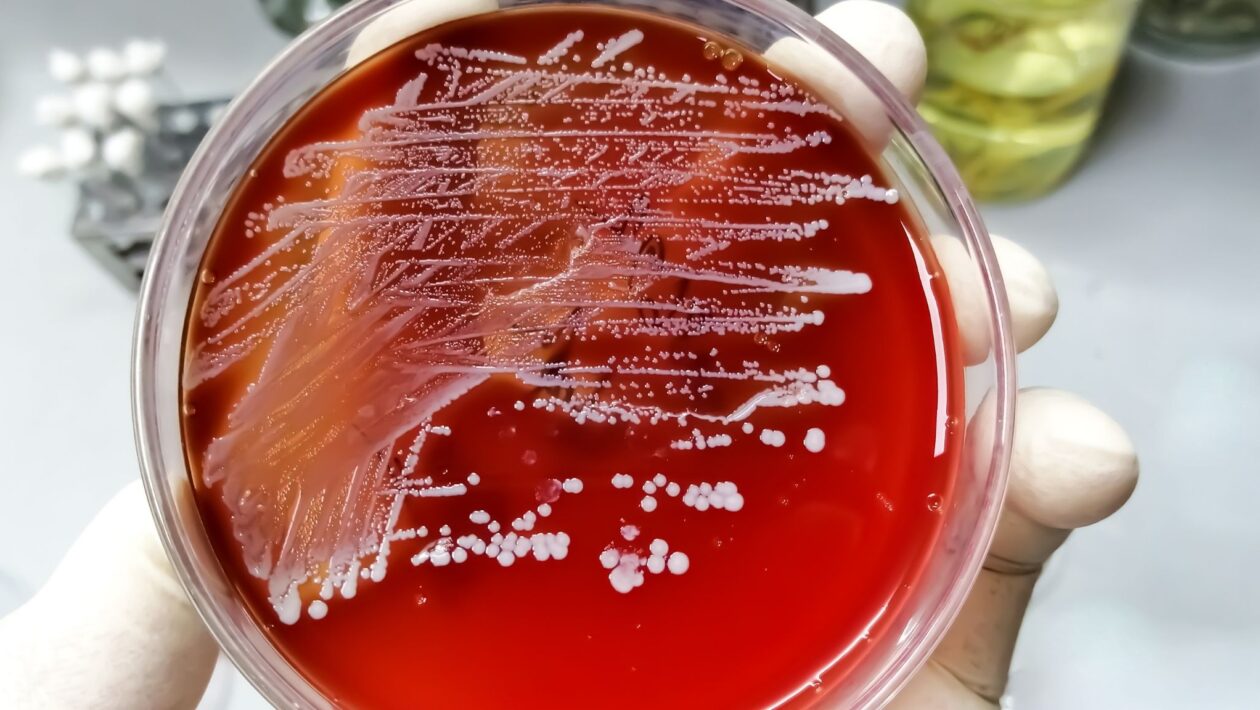

A notícia de novos casos da chamada “bactéria comedora de carne” tem gerado preocupação em vários países. A fasciíte necrosante é uma condição rara e grave, que exige atenção aos primeiros sinais e uma resposta médica rápida.
O que é a fasciíte necrosante
A fasciíte necrosante é uma infecção bacteriana agressiva que destrói tecidos moles, como pele, gordura e fáscia muscular. Em poucas horas, a infecção pode se espalhar e comprometer grandes áreas do corpo.
Na maioria dos casos, ela é causada por bactérias comuns no ambiente, como o Streptococcus do grupo A e o Staphylococcus aureus, presentes no solo, na água e até na pele humana. O perigo surge quando essas bactérias entram no organismo por meio de ferimentos, mesmo pequenos, como cortes, arranhões, bolhas ou picadas de inseto.
Como a infecção age no corpo

Depois de entrar na pele, as bactérias se multiplicam e liberam toxinas potentes que destroem tecidos e reduzem o fluxo sanguíneo local. Isso causa dor intensa, inchaço rápido e necrose, podendo levar à amputação se o tratamento não for imediato.
A mortalidade pode chegar a 30%, principalmente em pessoas com imunidade baixa, diabetes ou feridas mal cicatrizadas.
Sinais de alerta que exigem atenção médica
A fasciíte necrosante pode começar parecendo uma infecção simples, mas evolui rapidamente. Procure um médico se observar:
- Dor intensa e desproporcional ao tamanho do ferimento;
- Inchaço e vermelhidão que se espalham rapidamente;
- Febre alta, calafrios e fadiga;
- Bolhas, manchas escuras ou odor forte na área afetada.
Reconhecer esses sintomas precocemente é essencial para evitar complicações graves.
Como se proteger da bactéria “comedora de carne”
A melhor forma de prevenção é o cuidado adequado com a pele. Pequenas atitudes podem evitar grandes riscos:
- Lave qualquer ferida com água e sabão imediatamente;
- Cubra o ferimento com curativo limpo e seco até cicatrizar;
- Evite contato com água de rios, mares ou piscinas se houver cortes abertos;
- Busque atendimento médico rápido em caso de dor, febre ou vermelhidão crescente.
Situação no Brasil e no mundo
Embora a doença seja rara, autoridades de saúde de vários países têm observado aumento de casos desde a pandemia, possivelmente por fatores como imunossupressão e mudanças climáticas que favorecem a proliferação bacteriana.
No Brasil, não há registro oficial sobre a incidência, mas hospitais de grandes centros já notificaram casos esporádicos, principalmente após cirurgias ou traumas. A vigilância e a informação seguem sendo as melhores armas contra essa ameaça silenciosa.